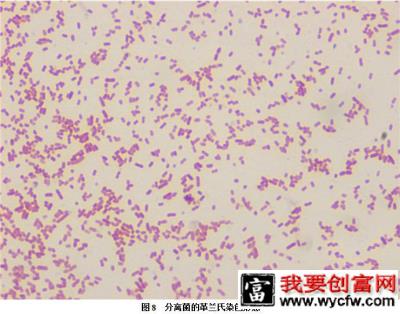

广东省珠海市斗门区白蕉镇灯笼村,一笋壳鱼(云斑尖塘鳢)养殖池塘,面积3.5亩,平均水深1.4米,2台1.5 kw增氧机(见图1)。2012年6月7日一次性放规格3 cm的笋壳鱼2.5万尾,8月11日过到其它塘1.5万尾。
2012年9月17日开始发病,刚开始一天死亡1~2尾,发病鱼规格约60克,从9月30日开始严重,每天死亡20~30尾。发病期间用过“鳃皮易康”,并用硫酸铜和“三氯异氰尿酸”杀虫消毒,但均无明显效果。
10月9日下午16:40分到现场检查,测定水温29.5℃。用简易测试盒测水质,pH值8.6,氨氮测不出,亚硝酸盐0.05 mg/L。从池中取3尾游水的笋壳鱼,外观其中2尾黑身,另外1尾头部皮肤溃烂,无其它明显病变(见图2)。解剖见鳃略微发白,有出血点(见图3);空肠空胃,胆囊肿大(见图4);脾脏发黑、肿大(见图5);肾脏肿大(见图6)。分别从病鱼的肝脏和肾脏中接种进行细菌分离培养,并取病鱼的脾脏和肾脏进行病毒检测和病理切片观察。
结果:从发病鱼的肝脏和肾脏中均分离出大量菌落形态单一的细菌(见图7),革兰氏染色呈阴性的短杆菌(见图8),从培养特性和染色初步鉴定为气单胞菌。从发病鱼的脾脏和肾脏均检测出真鲷虹彩病毒(见图9),病理切片可见肝脏严重水变性、淤血(见图10);脾脏淤血、出血,不见淋巴细胞,坏死,有肿大细胞(见图11);肾脏有肿大细胞,淋巴细胞散在坏死(见图12),肠有肿大细胞(见图13),鳃有嗜酸性大细胞,其鳃小片增生肿胀(图14)。
1、珠江所王庆等(2010)曾在发病死亡的笋壳鱼体内分离到肿大细胞病毒属虹彩病毒,并确定是发病病原,扩增序列与传染性脾肾坏死病毒(也叫真鲷虹彩病毒)全长序列的同源性最高,为98.8%。本病例中两尾黑身严重的笋壳鱼肝脏、脾脏、肾脏、肠道和鳃中均检出真鲷虹彩病毒,并从病理组织切片看具有真鲷虹彩病毒引起组织出现大量肿大细胞和脾肾坏死的致病特征。此外,细菌分离培养,3尾鱼均能分离出菌落形态大小一致的细菌,本病例发病笋壳鱼的死亡原因是真鲷虹彩病毒和气单胞菌混合感染引起。
2、近2年经常发生笋壳鱼大量发病死亡并用抗菌药物无效的情况,我们也在其它笋壳鱼发病病例中检测到真鲷虹彩病毒,可能该病毒对笋壳鱼的危害很大。(利洋研究所 雷燕 戚瑞荣 利洋水产药店白蕉店 黄英敬提供 2012.10.26)














2012年9月17日开始发病,刚开始一天死亡1~2尾,发病鱼规格约60克,从9月30日开始严重,每天死亡20~30尾。发病期间用过“鳃皮易康”,并用硫酸铜和“三氯异氰尿酸”杀虫消毒,但均无明显效果。
10月9日下午16:40分到现场检查,测定水温29.5℃。用简易测试盒测水质,pH值8.6,氨氮测不出,亚硝酸盐0.05 mg/L。从池中取3尾游水的笋壳鱼,外观其中2尾黑身,另外1尾头部皮肤溃烂,无其它明显病变(见图2)。解剖见鳃略微发白,有出血点(见图3);空肠空胃,胆囊肿大(见图4);脾脏发黑、肿大(见图5);肾脏肿大(见图6)。分别从病鱼的肝脏和肾脏中接种进行细菌分离培养,并取病鱼的脾脏和肾脏进行病毒检测和病理切片观察。
结果:从发病鱼的肝脏和肾脏中均分离出大量菌落形态单一的细菌(见图7),革兰氏染色呈阴性的短杆菌(见图8),从培养特性和染色初步鉴定为气单胞菌。从发病鱼的脾脏和肾脏均检测出真鲷虹彩病毒(见图9),病理切片可见肝脏严重水变性、淤血(见图10);脾脏淤血、出血,不见淋巴细胞,坏死,有肿大细胞(见图11);肾脏有肿大细胞,淋巴细胞散在坏死(见图12),肠有肿大细胞(见图13),鳃有嗜酸性大细胞,其鳃小片增生肿胀(图14)。
1、珠江所王庆等(2010)曾在发病死亡的笋壳鱼体内分离到肿大细胞病毒属虹彩病毒,并确定是发病病原,扩增序列与传染性脾肾坏死病毒(也叫真鲷虹彩病毒)全长序列的同源性最高,为98.8%。本病例中两尾黑身严重的笋壳鱼肝脏、脾脏、肾脏、肠道和鳃中均检出真鲷虹彩病毒,并从病理组织切片看具有真鲷虹彩病毒引起组织出现大量肿大细胞和脾肾坏死的致病特征。此外,细菌分离培养,3尾鱼均能分离出菌落形态大小一致的细菌,本病例发病笋壳鱼的死亡原因是真鲷虹彩病毒和气单胞菌混合感染引起。
2、近2年经常发生笋壳鱼大量发病死亡并用抗菌药物无效的情况,我们也在其它笋壳鱼发病病例中检测到真鲷虹彩病毒,可能该病毒对笋壳鱼的危害很大。(利洋研究所 雷燕 戚瑞荣 利洋水产药店白蕉店 黄英敬提供 2012.10.26)